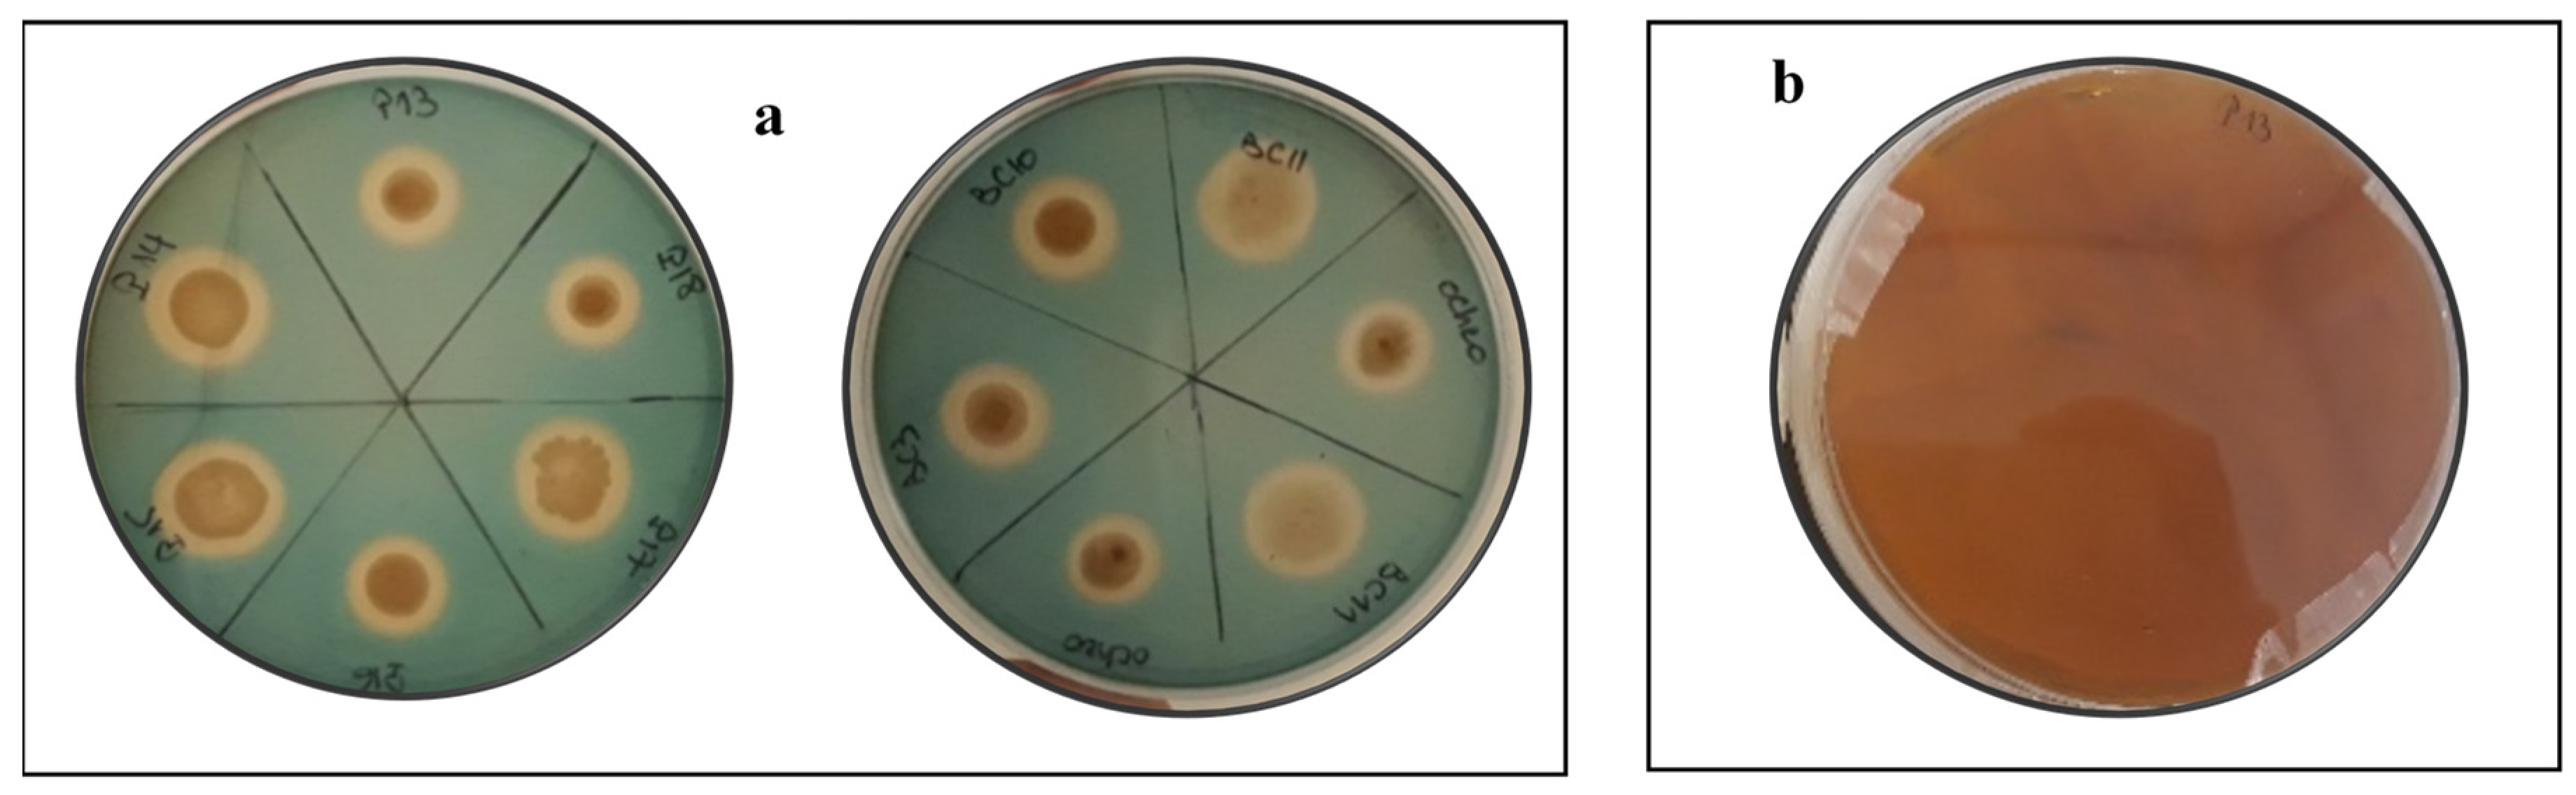
Microorganisms 09 00470 g004 Microorganisms 09 00470 g004

The Screening of Potassium- and Phosphate-Solubilizing Actinobacteria and the Assessment of Their Ability to Promote Wheat Growth Parameters
Abstract
1. Introduction
- (i)
- Assess the impact of the RP type and quality on the ability of Actinobacteria to solubilize P.
- (ii)
- Investigate the behavior of RP-solubilizing Actinobacteria under K-bearing minerals such as mica.
- (iii)
- Validate the impact of the RP–RK–Actinobacteria combination on plant growth under greenhouse conditions.
- (iv)
- Suggest efficient K- and P-solubilizing Actinobacteria strains as biofertilizers for sustainable improvement of plant nutrition and soil fertility.
2. Materials and Methods
2.1. Microbial Strains
2.2. Sampling and Characterization of Rock Phosphate
2.3. Screening for Rock Phosphate Solubilization
2.3.1. Qualitative Methods
2.3.2. Ability of the Actinobacteria Strains to Dissolve Rock Phosphates in Liquid Medium
2.4. Screening for Rock Potassium Solubilization
2.5. Dual Solubilization of Potassium and Phosphate
2.6. In Vitro Evaluation of Other Actinobacteria PGP Traits
2.6.1. Indole Acetic Acid (IAA) Production
2.6.2. Hydrogen Cyanide Production
2.6.3. Ammonia Production
2.6.4. Siderophore Production
2.7. Effect of Actinobacteria Strains on Wheat Germination: In-Vitro Tests
2.8. Greenhouse Experiment
2.9. Plant Analysis
2.10. Statistical Analysis
3. Results
3.1. Rock Phosphate Composition and Solubilization Index
3.2. Rock Phosphate Solubilization by the Actinobacteria Strains
3.3. Variations of pH during the Solubilization of Various RP Samples by the Actinobacteria Strains
3.4. Solubilization of Potassium by the Actinobacteria Strains
3.5. PGP Traits of Selected Actinobacteria Strains
3.5.1. IAA Production
3.5.2. HCN, Ammonia, and Siderophores Production
3.6. Germination and Vigor Index Improvement in Wheat Seedlings
3.7. Greenhouse Trials
4. Discussion
5. Conclusions
Author Contributions
Funding
Acknowledgments
Conflicts of Interest
References
- FAO. The State of Agricultural Commodity Markets—2018: Agricultural Trade, Climate Change and Food Security; FAO: Rome, Italy, 2018; ISBN 978-92-5-130565-2. [Google Scholar]
- MeCarty, S.C.; Chauhan, D.S.; Mecarty, A.D.; Tripathi, K.M.; Selvan, T.; Dubey, S.K. Effect of Azotobacter and phosphobacteria on yield of wheat (Triticum aestivum). Vegetos 2017, 30, 13–16. [Google Scholar] [CrossRef]
- Nath, M.; Bhatt, D.; Bhatt, M.D.; Prasad, R.; Tuteja, N. Microbe-Mediated Enhancement of Nitrogen and Phosphorus Content for Crop Improvement; Elsevier B.V.: Amsterdam, The Netherlands, 2018; pp. 293–304. ISBN 9780444639882. [Google Scholar]
- Maqsood, M.; Shehzad, M.A.; Wahid, A.; Butt, A.A. Improving drought tolerance in maize (Zea mays) with potassium application in furrow irrigation systems. Int. J. Agric. Biol. 2013, 15, 1193–1198. [Google Scholar]
- Bakhshandeh, E.; Pirdashti, H.; Lendeh, K.S. Phosphate and potassium-solubilizing bacteria effect on the growth of rice. Ecol. Eng. 2017, 103, 164–169. [Google Scholar] [CrossRef]
- Mitra, D.; Anđelković, S.; Panneerselvam, P.; Senapati, A.; Vasić, T.; Ganeshamurthy, A.N.; Chauhan, M.; Uniyal, N.; Mahakur, B.; Radha, T.K. Phosphate-Solubilizing Microbes and Biocontrol Agent for Plant Nutrition and Protection: Current Perspective. Commun. Soil Sci. Plant Anal. 2020, 51, 645–657. [Google Scholar] [CrossRef]
- Henri, F. Rock Phosphate Solubilisation by Strains of Penicillium Spp. Isolated from Farm and Forest Soils of three Agro Ecological Zones of Cameroon. Am. J. Agric. For. 2014, 2, 25. [Google Scholar] [CrossRef][Green Version]
- Rafique, M.; Sultan, T.; Ortas, I.; Chaudhary, H.J. Enhancement of maize plant growth with inoculation of phosphate solubilizing bacteria and biochar amendment in soil. Soil Sci. Plant Nutr. 2017, 63, 460–469. [Google Scholar] [CrossRef]
- Saleem, M.M.; Arshad, M.; Yaseen, M. Effectiveness of various approaches to use rock phosphate as a potential source of plant available P for sustainable wheat production. Int. J. Agric. Biol. 2013, 15, 223–230. [Google Scholar]
- Kaur, G.; Reddy, M.S. Effects of phosphate-solubilizing bacteria, rock phosphate and chemical fertilizers on maize-wheat cropping cycle and economics. Pedosphere 2015, 25, 428–437. [Google Scholar] [CrossRef]
- Numan, M.; Bashir, S.; Khan, Y.; Mumtaz, R.; Shinwari, Z.K.; Khan, A.L.; Khan, A.; Ahmed, A.H. Plant growth promoting bacteria as an alternative strategy for salt tolerance in plants: A review. Microbiol. Res. 2018, 209, 21–32. [Google Scholar] [CrossRef]
- Bargaz, A.; Lyamlouli, K.; Chtouki, M.; Zeroual, Y.; Dhiba, D. Soil Microbial Resources for Improving Fertilizers Efficiency in an Integrated Plant Nutrient Management System. Front. Microbiol. 2018, 9, 1606. [Google Scholar] [CrossRef]
- Umesha, S.; Manukumar, H.M. Advanced molecular diagnostic techniques for detection of food-borne pathogens: Current applications and future challenges. Crit. Rev. Food Sci. Nutr. 2018, 58, 84–104. [Google Scholar] [CrossRef] [PubMed]
- Franco-Correa, M.; Quintana, A.; Duque, C.; Suarez, C.; Rodríguez, M.X.; Barea, J.M. Evaluation of actinomycete strains for key traits related with plant growth promotion and mycorrhiza helping activities. Appl. Soil Ecol. 2010, 45, 209–217. [Google Scholar] [CrossRef]
- de Jesus Sousa, J.A.; Olivares, F.L. Plant growth promotion by Streptomycetes: Ecophysiology, mechanisms and applications. Chem. Biol. Technol. Agric. 2016, 3, 24. [Google Scholar] [CrossRef]
- Gong, Y.; Bai, J.L.; Yang, H.T.; Zhang, W.D.; Xiong, Y.W.; Ding, P.; Qin, S. Phylogenetic diversity and investigation of plant growth-promoting traits of actinobacteria in coastal salt marsh plant rhizospheres from Jiangsu, China. Syst. Appl. Microbiol. 2018, 41, 516–527. [Google Scholar] [CrossRef] [PubMed]
- Soumare, A.; Boubekri, K.; Lyamlouli, K.; Hafidi, M.; Ouhdouch, Y.; Kouisni, L. From Isolation of Phosphate Solubilizing Microbes to Their Formulation and Use as Biofertilizers: Status and Needs. Front. Bioeng. Biotechnol. 2020, 7, 1–14. [Google Scholar] [CrossRef] [PubMed]
- Yekkour, A.; Sabaou, N.; Zitouni, A.; Errakhi, R.; Mathieu, F.; Lebrihi, A. Characterization and antagonistic properties of Streptomyces strains isolated from Saharan soils, and evaluation of their ability to control seedling blight of barley caused by Fusarium culmorum. Lett. Appl. Microbiol. 2012, 55, 427–435. [Google Scholar] [CrossRef]
- Nandimath, A.P.; Karad, D.D.; Gupta, S.G.; Kharat, A.S. Consortium inoculum of five thermo-tolerant phosphate solubilizing actinomycetes for multipurpose biofertilizer preparation. Iran. J. Microbiol. 2017, 9, 295–304. [Google Scholar]
- Sharma, M.; Dangi, P.; Choudhary, M. Actinomycetes: Source, Identification, and Their Applications. Int. J. Curr. Microbiol. Appl. Sci. 2014, 3, 801–832. [Google Scholar]
- Trenozhnikova, L.; Azizan, A. Discovery of Actinomycetes from Extreme Environments with Potential to Produce Novel Antibiotics. Cent. Asian J. Glob. Health 2018, 7, 1. [Google Scholar] [CrossRef]
- AbdElgawad, H.; Saleh, A.M.; Al Jaouni, S.; Selim, S.; Hassan, M.O.; Wadaan, M.A.M.; Shuikan, A.M.; Mohamed, H.S.; Hozzein, W.N. Utilization of actinobacteria to enhance the production and quality of date palm (Phoenix dactylifera L.) fruits in a semiarid environment. Sci. Total Environ. 2019, 665, 690–697. [Google Scholar] [CrossRef]
- El-Tarabily, K.A.; Hardy, G.E.S.J.; Sivasithamparam, K. Performance of three endophytic actinomycetes in relation to plant growth promotion and biological control of Pythium aphanidermatum, a pathogen of cucumber under commercial field production conditions in the United Arab Emirates. Eur. J. Plant Pathol. 2010, 128, 527–539. [Google Scholar] [CrossRef]
- Rani, K.; Dahiya, A.; Masih, J.C.; Wati, L. Actinobacterial Biofertilizers: An Alternative Strategy for Plant Growth Promotion. Int. J. Curr. Microbiol. Appl. Sci. 2018, 7, 607–614. [Google Scholar] [CrossRef]
- Yadav, N.; Yadav, A.N. Actinobacteria for sustainable agriculture. J. Appl. Biotechnol. Bioeng. 2019, 6, 48–51. [Google Scholar]
- Nautiyal Shekhar, C. An efficient microbiological growth medium for screening phosphate solubilizing microorganisms. FEMS Microbiol. Lett. 1999, 170, 265–270. [Google Scholar] [CrossRef]
- Afzal, A.; Bano, A. Rhizobium and phosphate solubilizing bacteria improve the yield and phosphorus uptake in wheat (Triticum aestivum). Int. J. Agric. Biol. 2008, 10, 85–88. [Google Scholar]
- Nagul, E.A.; McKelvie, I.D.; Worsfold, P.; Kolev, S.D. The molybdenum blue reaction for the determination of orthophosphate revisited: Opening the black box. Anal. Chim. Acta 2015, 890, 60–82. [Google Scholar] [CrossRef]
- Meena, V.S.; Maurya, B.R.; Verma, J.P.; Aeron, A.; Kumar, A.; Kim, K.; Bajpai, V.K. Potassium solubilizing rhizobacteria (KSR): Isolation, identification, and K-release dynamics from waste mica. Ecol. Eng. 2015, 81, 340–347. [Google Scholar] [CrossRef]
- Othman, R.; Mohd, H.; Saud, M.; Habib, S.H. Isolation and characterization of rhizobia and plant growth-promoting rhizobacteria and their effects on growth of rice seedlings. Am. J. Agric. Biol. Sci. 2014, 9, 342–360. [Google Scholar]
- Sachdev, D.P.; Chaudhari, H.G.; Kasture, V.M.; Dhavale, D.D.; Chopade, B.A. Isolation and characterization of indole acetic acid (IAA) producing Klebsiella pneumoniae strains from rhizosphere of wheat (Triticum aestivum) and their effect on plant growth. Indian J. Exp. Biol. 2009, 47, 993–1000. [Google Scholar]
- Rodrigues, A.A.; Araujo, M.V.F.; Soares, M.D.S.; De Oliveira, B.F.R.; Sibov, S.T.; Vieira, J.D.G. Isolation and Screening for Multitrait Plant Growth Promoting Actinobacteria From Organic Sugarcane Rhizosphere. Int. J. Microbiol. Res. 2018, 10, 1193. [Google Scholar] [CrossRef]
- Passari, A.K.; Mishra, V.K.; Gupta, V.K.; Yadav, M.K.; Saikia, R.; Singh, B.P. In vitro and in vivo plant growth promoting activities and DNA fingerprinting of antagonistic endophytic actinomycetes associates with medicinal plants. PLoS ONE 2015, 10, e0139468. [Google Scholar] [CrossRef] [PubMed]
- Cappuccino, J.C.; Sherman, N. Microbiology: A Laboratory Manual, 3rd ed.; Benjamin/Cummings Pub. Co.: New York, NY, USA, 1992; pp. 125–179. [Google Scholar]
- Schwyn, B.; Neilands, J.B. Universal chemical assay for the detection and determination of siderophores. Anal. Biochem. 1987, 160, 47–56. [Google Scholar] [CrossRef]
- Lynne, A.M.; Haarmann, D.; Louden, B.C. Use of Blue Agar CAS Assay for Siderophore Detection. J. Microbiol. Biol. Educ. 2011, 12, 51–53. [Google Scholar]
- de Amaral Leite, A.; de Souza Cardoso, A.A.; de Almeida Leite, R.; de Oliveira-Longatti, S.M.; Lustosa Filho, J.F.; de Souza Moreira, F.M.; Melo, L.C.A. Selected bacterial strains enhance phosphorus availability from biochar-based rock phosphate fertilizer. Ann. Microbiol. 2020, 70, 1–13. [Google Scholar] [CrossRef]
- Hoagland, D.R.; Arnon, D.I. The water culture method for growing plants without soil. Circular. Calif. Agric. Exp. Stn. 1950, 347, 29–31. [Google Scholar]
- Khosro, M.; Yousef, S. Bacterial Biofertilizers for Sustainable Crop Production: A Review. J. Agric. Biol. Sci. 2012, 7, 307–316. [Google Scholar]
- Dhanasekaran, D.; Jiang, Y. Actinobacteria—Basics and Biotechnological Applications; BoD–Books on Demand: Norderstedt, Germany, 2016; ISBN 9789537619343. [Google Scholar]
- Djebaili, R.; Pellegrini, M.; Smati, M.; Del Gallo, M.; Kitouni, M. Actinomycete strains isolated from saline soils: Plant-growth promoting traits and inoculation effects on solanum lycopersicum. Sustainability 2020, 12, 4617. [Google Scholar] [CrossRef]
- Hamdali, H.; Bouizgarne, B.; Hafidi, M.; Lebrihi, A.; Virolle, M.J.; Ouhdouch, Y. Screening for rock phosphate solubilizing Actinomycetes from Moroccan phosphate mines. Appl. Soil Ecol. 2008, 38, 12–19. [Google Scholar] [CrossRef]
- Nafis, A.; Raklami, A.; Bechtaoui, N.; El Khalloufi, F.; El Alaoui, A.; Glick, B.R.; Hafidi, M.; Kouisni, L.; Ouhdouch, Y.; Hassani, L. Actinobacteria from Extreme Niches in Morocco and Their Plant Growth-Promoting Potentials. Diversity 2019, 11, 139. [Google Scholar] [CrossRef]
- Subramaniam, G.; Arumugam, S.; Rajendran, V. Plant Growth Promoting Actinobacteria: A New Avenue for Enhancing the Productivity and Soil Fertility of Grain Legumes; Springer: Berlin/Heidelberg, Germany, 2016; pp. 1–298. [Google Scholar]
- Welch, S.A.; Taunton, A.E.; Banfield, J.F. Effect of microorganisms and microbial metabolites on apatite dissolution. Geomicrobiol. J. 2002, 19, 343–367. [Google Scholar] [CrossRef]
- Hamdali, H.; Hafidi, M.; Virolle, M.J.; Ouhdouch, Y. Rock phosphate solubilizing Actinomycetes: Screening for plant growth promoting activities. World J. Microbiol. Biotechnol. 2008, 24, 2565–2575. [Google Scholar] [CrossRef]
- Karlidag, H.; Esitken, A.; Turan, M.; Sahin, F. Effects of root inoculation of plant growth promoting rhizobacteria (PGPR) on yield, growth and nutrient element contents of leaves of apple. Sci. Hortic. 2007, 114, 16–20. [Google Scholar] [CrossRef]
- Kumari, K.; Phogat, V. Rock phosphate: Its availability and solubilization in the soil—A review. Agric. Rev. 2008, 29, 108–116. [Google Scholar]
- Verma, P.; Yadav, A.N.; Khannam, K.S.; Kumar, S.; Saxena, A.K.; Suman, A. Molecular diversity and multifarious plant growth promoting attributes of Bacilli associated with wheat (Triticum aestivum L.) rhizosphere from six diverse agro-ecological zones of India. J. Basic Microbiol. 2016, 56, 44–58. [Google Scholar] [CrossRef] [PubMed]
- Verma, P.; Yadav, A.N.; Khannam, K.S.; Mishra, S.; Kumar, S.; Saxena, A.K.; Suman, A. Appraisal of diversity and functional attributes of thermotolerant wheat associated bacteria from the peninsular zone of India. Saudi J. Biol. Sci. 2019, 26, 1882–1895. [Google Scholar] [CrossRef]
- Etesami, H.; Emami, S.; Alikhani, H.A. Potassium solubilizing bacteria (KSB): Mechanisms, promotion of plant growth, and future prospects—A review. J. Soil Sci. Plant Nutr. 2017, 17, 897–911. [Google Scholar] [CrossRef]
- Merchant, S.S.; Helmann, J.D. Elemental Economy. Microbial Strategies for Optimizing Growth in the Face of Nutrient Limitation. Adv. Microb. Physiol. 2012, 60, 91–210. [Google Scholar]
- Abou-el-Seoud, I.I.; Abdel-Megeed, A. Impact of rock materials and biofertilizations on P and K availability for maize (Zea Maize) under calcareous soil conditions. Saudi J. Biol. Sci. 2012, 19, 55–63. [Google Scholar] [CrossRef]
- Singh, D.P.; Singh, H.B.; Prabha, R. Microbial Inoculants in Sustainable Agricultural Productivity: Vol. 1: Research Perspectives; Springer: New Delhi, India, 2016; Volume 1, pp. 1–343. [Google Scholar]
- Glick, B.R. Plant Growth-Promoting Bacteria: Mechanisms and Applications. Scientifica 2012, 2012, 963401. [Google Scholar] [CrossRef]
- Duca, D.; Lorv, J.; Patten, C.L.; Rose, D.; Glick, B.R. Indole-3-acetic acid in plant-microbe interactions. Antonie Leeuwenhoek Int. J. Gen. Mol. Microbiol. 2014, 106, 85–125. [Google Scholar] [CrossRef]
- Lasudee, K.; Tokuyama, S.; Lumyong, S.; Pathom-Aree, W. Actinobacteria Associated with arbuscular mycorrhizal funneliformis mosseae spores, taxonomic characterization and their beneficial traits to plants: Evidence obtained from mung bean (Vigna radiata) and Thai Jasmine Rice (Oryza sativa). Front. Microbiol. 2018, 9, 1–18. [Google Scholar] [CrossRef] [PubMed]
- Doumbou, C.L.; Hamby Salove, M.K.; Crawford, D.L.; Beaulieu, C. Actinomycetes, promising tools to control plant diseases and to promote plant growth. Phytoprotection 2001, 82, 85–102. [Google Scholar] [CrossRef]
- Demissie, S.; Muleta, D.; Berecha, G. Effect of phosphate solubilizing bacteria on seed germination and seedling growth of Faba bean (Vicia faba L.). Int. J. Agric. Res. 2013, 8, 123–136. [Google Scholar] [CrossRef][Green Version]
- Sharma, K.; Dak, G.; Agrawal, A.; Bhatnagar, M.; Sharma, R. Effect of Phosphate Solubilizing Bacteria on the Germination of Cicer arietinum Seeds and Seedling Growth. J. Herb. Med. Toxicol. 2007, 1, 61–63. [Google Scholar]
- Ahemad, M.; Kibret, M. Mechanisms and applications of plant growth promoting rhizobacteria: Current perspective. J. King Saud Univ. Sci. 2014, 26, 1–20. [Google Scholar] [CrossRef]
- Soumare, A.; Boubekri, K.; Lyamlouli, K.; Hafidi, M.; Ouhdouch, Y.; Kouisni, L. Efficacy of phosphate solubilizing Actinobacteria to improve rock phosphate agronomic effectiveness and plant growth promotion. Rhizosphere 2020, 17, 100284. [Google Scholar] [CrossRef]
- Sreevidya, M.; Gopalakrishnan, S.; Kudapa, H.; Varshney, R.K. Exploring plant growth-promotion actinomycetes from vermicompost and rhizosphere soil for yield enhancement in chickpea. Braz. J. Microbiol. 2016, 47, 85–95. [Google Scholar] [CrossRef]
- El-Tarabily, K.A. Promotion of tomato (Lycopersicon esculentum Mill.) plant growth by rhizosphere competent 1- aminocyclopropane-1-carboxylic acid deaminase-producing Streptomycetes actinomycetes. Plant Soil 2008, 308, 161–174. [Google Scholar] [CrossRef]
- Gopalakrishnan, S.; Pande, S.; Sharma, M.; Humayun, P.; Kiran, B.K.; Sandeep, D.; Vidya, M.S.; Deepthi, K.; Rupela, O. Evaluation of actinomycete isolates obtained from herbal vermicompost for the biological control of Fusarium wilt of chickpea. Crop Prot. 2011, 30, 1070–1078. [Google Scholar] [CrossRef]

| Strains Code | % Sequence Identities | Actinobacteria Strains | Accession Number |
|---|---|---|---|
| P13 | 99% | Streptomyces fulvissimus | MT845224 |
| P14 | 99% | Streptomyces youssoufiensis | MT845225 |
| P15 | 99% | Streptomyces microflavus | MT845226 |
| P16 | 99% | Streptomyces anulatus | MT845227 |
| P17 | 99% | Streptomyces pratensis | MT845228 |
| P18 | 99% | Streptomyces alboviridis | MT845229 |
| BC3 | 100% | Streptomyces griseorubens | MT845230 |
| BC10 | 99% | Streptomyces griseorubens | MT845231 |
| BC11 | 100% | Nocardiopsis alba | MT845232 |
| Strain Code | Diameter of Halo Zone (mm) | Diameter of Colony (mm) | Solubilization Index |
|---|---|---|---|
| P13 | 1.6 | 1.4 | 2.14 |
| P14 | 3 | 1.75 | 2.71 |
| P15 | 2.1 | 1.5 | 2.4 |
| P16 | 2.5 | 1.15 | 3.17 |
| P17 | 5.6 | 3 | 2.86 |
| P18 | – | – | – |
| BC3 | 2.9 | 1.6 | 2.81 |
| BC10 | 3.3 | 1.6 | 3.06 |
| BC11 | 2.8 | 2.15 | 2.3 |
| Strains | AIA Production | Siderophore Production (cm) | HCN Production | Ammonia Production | ||
|---|---|---|---|---|---|---|
| 3 Days | 7 Days | 11 Days | ||||
| P13 | −1.11 ± 0.40 d | −0.53 ± 0.23 f | 1.73 ± 0.18 h | 1.461 ± 0.00 | + + + | + |
| P14 | 51.45 ± 2.76 b | 88.74 ± 1.17 b | 57.92 ± 1.75 d | 1.454 ± 0.21 | + | + |
| P15 | −1.5 ± 1.07 d | 7.49 ± 2.24 de | 16.77 ± 0.82 e | 1.393 ± 0.07 | + + | + + |
| P16 | −3.64 ± 0.22 d | 41.74 ± 1.77 c | 57.73 ± 0.89 d | 1.555 ± 0.00 | + + | + |
| P17 | −2.28 ± 0.28 d | 9.57 ± 0.46 d | 10.61 ± 0.14 f | 1.333 ± 0.21 | + + | + |
| P18 | 82.92 ± 1.5 a | 44.31 ± 1.49 c | 66 ± 0.38 c | 1.477 ± 0.28 | + + | + + |
| BC3 | 10.02 ± 2.34 c | 2.68 ±0.5 e | 3.19 ± 0.09 g | 1.736 ± 0.00 | + | + |
| BC10 | 6.30 ± 2.47 c | 128.44 ± 4.08 a | 72.98 ± 0.27 b | 1.348 ± 0.00 | + + | + + |
| BC11 | 7.57 ± 2.48 c | 10.65 ± 1.41 d | 82.33 ± 0.84 a | 1.552 ± 0.00 | + | + |
| Treatments | Shoot Lengths | Root Lengths | Germination Rate * | Vigor Index |
|---|---|---|---|---|
| Negative control | 2.4 ± 0.82 c | 1.9 ± 0.96 d | 80 | |
| Control (RP) | 5.14 ± 1.61 ab | 3.3 ± 0.97 bcd | 85 | 9.92% |
| P13 | 5.6 ± 0.54 ab | 2.98 ± 0.94 cd | 90 | 9.53% |
| P14 | 5.2 ± 1.75 ab | 3.1 ± 0.54 bcd | 85 | 9.76% |
| P15 | 4.34 ± 0.76 bc | 3.4 ± 0.89 bcd | 85 | 9.10% |
| P16 | 3.9 ± 0.89 bc | 2.1 ± 0.41 d | 90 | 6.66% |
| P17 | 5.6 ± 0.54 ab | 3.7 ± 0.83 bcd | 85 | 10.94% |
| P18 | 7.2 ± 0.83 a | 6.5 ± 0.70 a | 100 | 13.7% |
| BC3 | 5.9 ± 1.34 ab | 2.6 ± 0.22 cd | 100 | 8.5% |
| BC10 | 5.5 ± 0.7 ab | 4.1 ± 1.19 cd | 100 | 9.6% |
| BC11 | 6.1 ± 0.74 ab | 4.7 ± 1.35 ab | 100 | 10.8% |
| Treatments | Effect of RP and Actinobacteria Inoculation | ||
|---|---|---|---|
| Plumule Length Increase | Root Length Increase | Vigor Index Increase | |
| Negative control | |||
| Control (RP) | |||
| P13 + RP | +7.14% | +51% | 11.66% (+2.13) |
| P14 + RP | +15.38% | +37.09% | 12.05% (+2.29) |
| P15 + RP | +42.85% | +52.94% | 16.17% (+ 7.07) |
| P16 + RP | +34.61% | +90.47% | 9.44% (+ 2.78) |
| P17 + RP | +20.53% | +14.86% | 12.64% (+1.7) |
| P18 + RP | +31.94% | +15.38% | 17% (+3.3) |
| BC3 + RP | +86.44% | +92.3% | 16% (+7.5) |
| BC10 + RP | +72.72% | +101.21% | 17.75% (+8.15) |
| BC11 + RP | +66.66% | +70.21% | 18.5% (+7.7) |
| Treatments | Shoot Length (cm) | Root Length (cm) | Shoot Dry Weight (g/plant) | Root Dry Weight (g/plant) | Root Volume (cm3) |
|---|---|---|---|---|---|
| C− | 23.85 ± 0.96 d | 46.15 ± 2.57 c | 0.2355 ± 0.03 d | 0.273 ± 0.042 c | 1.12 ± 0.12 e |
| C+ (TSP) | 60 ± 2.96 a | 48.12 ± 6.12 bc | 3.22 ± 0.35 a | 1.154 ± 0.315 a | 2.93 ± 0.420 ab |
| Mica | 55.95 ± 1.95 a | 49.56 ± 6.24 bc | 2.51 ± 0.381 b | 1.717 ± 0.407 a | 3.131 ± 0.06 a |
| C (Mica + RP) | 32.775 ± 1.77 c | 56.32 ±7.41 ab | 0.507 ± 0.085 cd | 0.29 ± 0.45 bc | 1.335 ± 0.255 cde |
| RP | 32.75 ± 3.15 c | 50.59 ± 7.70 bc | 0.399 ± 0.08 cd | 0.282 ± 0.064 bc | 1.33 ± 0.18 de |
| P18 | 36.55 ± 2.60 bc | 57.31 ± 5.06 ab | 0.520 ± 0.03 cd | 0.426 ± 0.066 bc | 1.937 ± 0.2 bcde |
| BC3 | 35.7 ± 2.74 bc | 68 ± 8.79 a | 0.574 ± 0.083 cd | 0.45 ± 0.046 bc | 2.289 ± 0.68 abcd |
| BC10 | 40.5 ± 6.087 b | 67.22 ± 9.15 a | 0.82 ± 0.12 c | 0.761 ± 0.147 b | 2.192 ± 0.417 abc |
| BC11 | 39.45 ± 3.09 b | 69.75 ± 1.68 a | 0.84 ± 0.06 c | 0.528 ± 0.049 bc | 1.89 ± 0.302 cde |
Publisher’s Note: MDPI stays neutral with regard to jurisdictional claims in published maps and institutional affiliations. |
© 2021 by the authors. Licensee MDPI, Basel, Switzerland. This article is an open access article distributed under the terms and conditions of the Creative Commons Attribution (CC BY) license (http://creativecommons.org/licenses/by/4.0/).
Share and Cite
Boubekri, K.; Soumare, A.; Mardad, I.; Lyamlouli, K.; Hafidi, M.; Ouhdouch, Y.; Kouisni, L. The Screening of Potassium- and Phosphate-Solubilizing Actinobacteria and the Assessment of Their Ability to Promote Wheat Growth Parameters. Microorganisms 2021, 9, 470. https://doi.org/10.3390/microorganisms9030470
Boubekri K, Soumare A, Mardad I, Lyamlouli K, Hafidi M, Ouhdouch Y, Kouisni L. The Screening of Potassium- and Phosphate-Solubilizing Actinobacteria and the Assessment of Their Ability to Promote Wheat Growth Parameters. Microorganisms. 2021; 9(3):470. https://doi.org/10.3390/microorganisms9030470
Chicago/Turabian StyleBoubekri, Kenza, Abdoulaye Soumare, Ilham Mardad, Karim Lyamlouli, Mohamed Hafidi, Yedir Ouhdouch, and Lamfeddal Kouisni. 2021. "The Screening of Potassium- and Phosphate-Solubilizing Actinobacteria and the Assessment of Their Ability to Promote Wheat Growth Parameters" Microorganisms 9, no. 3: 470. https://doi.org/10.3390/microorganisms9030470
APA StyleBoubekri, K., Soumare, A., Mardad, I., Lyamlouli, K., Hafidi, M., Ouhdouch, Y., & Kouisni, L. (2021). The Screening of Potassium- and Phosphate-Solubilizing Actinobacteria and the Assessment of Their Ability to Promote Wheat Growth Parameters. Microorganisms, 9(3), 470. https://doi.org/10.3390/microorganisms9030470

